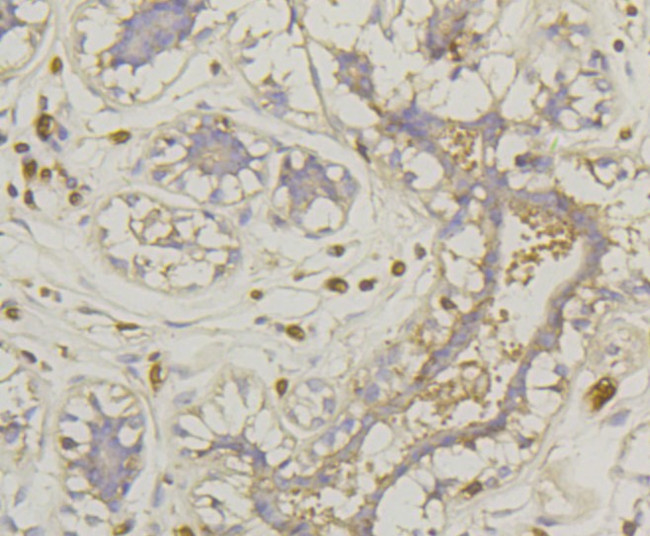
Glucose Transporter GLUT1 Antibody in Immunohistochemistry (Paraffin) (IHC (P))

Search
Bioss
Glucose Transporter GLUT1 Monoclonal Antibody (2D5)
{{$productOrderCtrl.translations['antibody.pdp.commerceCard.promotion.promotions']}}
{{$productOrderCtrl.translations['antibody.pdp.commerceCard.promotion.viewpromo']}}
{{$productOrderCtrl.translations['antibody.pdp.commerceCard.promotion.promocode']}}: {{promo.promoCode}} {{promo.promoTitle}} {{promo.promoDescription}}. {{$productOrderCtrl.translations['antibody.pdp.commerceCard.promotion.learnmore']}}
图: 1 / 6
Glucose Transporter GLUT1 Antibody (BSM-52240R) in IHC (P)






产品信息
BSM-52240R
宿主/亚型
分类
类型
克隆号
抗原
偶联物
形式
浓度
保存条件
运输条件
靶标信息
Glucose transporter 1 (GLUT1), encoded by the SLC2A1 gene, is a facilitative glucose transporter that plays a pivotal role in the uptake of glucose across cell membranes, particularly in tissues with high-energy demands such as the brain, erythrocytes, and endothelial cells of the blood-brain barrier. GLUT1 is ubiquitously expressed and functions through a passive diffusion mechanism, allowing glucose to move down its concentration gradient. Its involvement in maintaining glucose homeostasis is crucial for cellular metabolism and energy production. Mutations in SLC2A1 can lead to GLUT1 deficiency syndrome, characterized by seizures, developmental delay, and movement disorders due to impaired glucose transport into the brain. GLUT1 also plays a significant role in cancer biology, where its overexpression is commonly observed in various tumors, facilitating the enhanced glucose uptake required for rapid tumor cell proliferation. This characteristic makes GLUT1 a potential target for cancer diagnostics and therapeutics. Additionally, GLUT1's regulation is influenced by factors such as hypoxia, insulin, and cellular stress, highlighting its adaptive role in different physiological and pathological states.
仅用于科研。不用于诊断过程。未经明确授权不得转售。